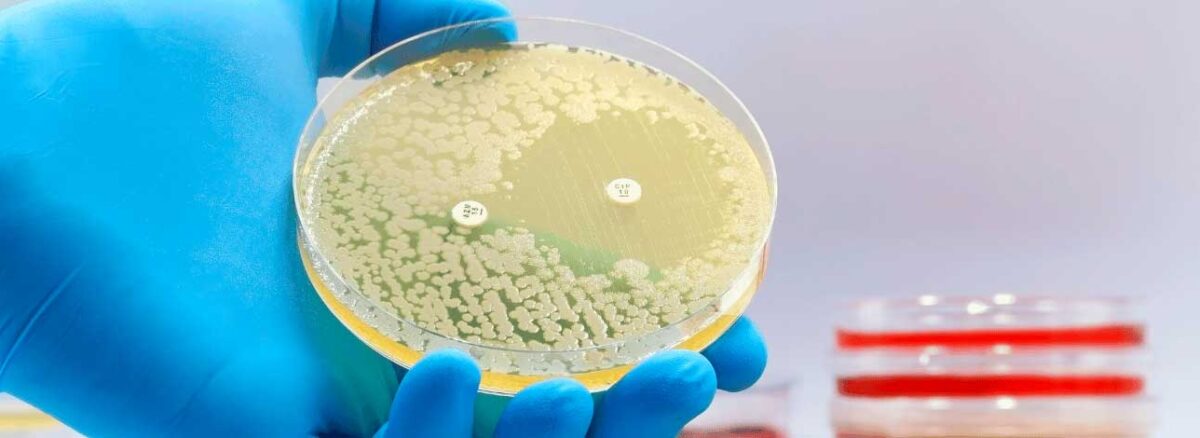

- 15 de outubro de 2024
- SPX Imagem
- Comment: 0
- News Médicos, Notícias, SPX, Explica
Estudo: Resistência a Antibióticos Pode Matar 39 Milhões Até 2050
Segundo análise científica, a resistência a antibióticos pode ser um grande problema nos próximos anos. Entenda como!
Um estudo publicado na revista científica The Lancet na última segunda-feira (16) estima que até 2050, mais de 39 milhões de mortes poderão ocorrer devido a infecções resistentes a antibióticos. A análise, então
conduzida pelo Projeto Global Research on Antimicrobial Resistance (GRAM), é a primeira a explorar detalhadamente os impactos globais da resistência antimicrobiana na saúde pública.
As conclusões do estudo ressaltam a urgência de ações preventivas, bem como vacinação, combate ao uso indevido de antibióticos e o desenvolvimento de novos medicamentos. Em síntese, essas medidas são essenciais para reduzir o número de mortes relacionadas à resistência antimicrobiana, um problema que ameaça a saúde global nas próximas décadas.
Dados Relevantes sobre a Resistência a Antibióticos

A análise revela que, entre 1990 e 2021, mais de um milhão de pessoas em todo o mundo perderam a vida devido à resistência a antibióticos. Durante esse período, as mortes entre crianças menores de cinco anos apresentaram uma queda de 50%, enquanto o número de óbitos entre pessoas com 70 anos ou mais aumentou em mais de 80%.
Além disso, o estudo traz previsões alarmantes para o futuro. As mortes diretamente atribuídas à resistência antimicrobiana devem aumentar de forma contínua nas próximas décadas. O crescimento projetado é de quase 70% até 2050 em comparação a 2022, afetando principalmente a população idosa.
Analogamente, as mortes nas quais as bactérias resistentes a antibióticos desempenham um papel — ou seja, as mortes indiretas — podem aumentar em quase 75%, passando de 4,71 milhões para 8,22 milhões por ano nesse mesmo período.
“Entender como as tendências nas mortes por RAM [resistência antimicrobiana] mudaram ao longo do tempo e como elas provavelmente mudarão no futuro é vital para tomar decisões informadas para salvar vidas.”
– Mohsen Naghavi, líder da equipe de pesquisa de RAM no Institute of Health Metrics (IHME), Universidade de Washington, nos Estados Unidos
Resistência Antimicrobiana: Estudo com 22 Patógenos
O estudo em questão, portanto, gerou estimativas para 22 patógenos, 84 combinações de patógenos e medicamentos, e 11 síndromes infecciosas, que incluem meningite e infecções da corrente sanguínea, entre outras. Essas estimativas foram eventualmente fundamentadas em 520 milhões de registros individuais provenientes de diversas fontes.
Para produzir as estimativas de mortes diretamente relacionadas à resistência a antibióticos e aquelas em que a condição foi um fator contribuinte, foi utilizada uma modelagem estatística. Assim, com base em tendências históricas, os pesquisadores calcularam os impactos globais e regionais da resistência antimicrobiana (RAM) na saúde entre 2022 e 2050.
Além disso, foram igualmente elaboradas previsões para cenários em que a qualidade da assistência médica e o acesso a antibióticos melhorem, assim como para o desenvolvimento de medicamentos direcionados a bactérias gram-negativas.
Patógenos Críticos
Como resultado, o estudo identificou seis dos sete patógenos classificados pela OMS como os mais difíceis de tratar, destacando, assim, sua importância crítica e o risco significativo de morte associado a eles. Um exemplo alarmante é a Staphylococcus aureus resistente à meticilina, cujas mortes aumentaram globalmente de 57.200 em 1990 para 130 mil em 2021.
Entre as bactérias gram-negativas, que são notoriamente resistentes a medicamentos antimicrobianos, a resistência aos carbapenêmicos apresentou um crescimento acentuado, passando de 127 mil mortes em 1990 para 216 mil em 2021. Logo, esses dados ressaltam a gravidade da resistência a antibióticos e a necessidade urgente de medidas eficazes para combatê-la.
Quais as Projeções Futuras?
Por último, os autores projetam um aumento contínuo nas mortes relacionadas à resistência antimicrobiana (RAM) nas próximas décadas. Até 2050, estima-se que as mortes anuais diretamente atribuídas à RAM alcancem 1,91 milhão, um crescimento de 67,5% em relação às 1,14 milhões registradas em 2021.
Da mesma forma, a RAM deverá estar envolvida em 8,22 milhões de mortes adicionais. Isso representa um aumento de 74,5% em comparação com as 4,71 milhões associadas em 2021.
Embora a mortalidade entre crianças menores de cinco anos deva continuar a cair, com uma redução de 49,6% até 2050, os idosos acima de 70 anos enfrentarão um aumento significativo nos óbitos relacionados à RAM. Subiria de 512.353 para 1.259.409 mortes, especialmente em países de alta renda.
Referência: CNN Brasil.
Participe do Canal do WhatsApp da SPX!
Gostou? Clique aqui e acompanhe outros conteúdos da SPX Clínica. Dicas de saúde, novidades e muito mais. Fique por dentro do mundo da saúde!
Últimas Notícias

Outubro Rosa: Por Que as Mulheres Ainda Evitam Exames?
Apesar do conhecimento da campanha de conscientização de outubro, muitas mulheres ainda evitam exames de cuidado da saúde feminina

Quais Condições o Dermatologista pode Tratar?
Nossa pele requer atenção e cuidados constantes e, sendo assim, vamos conhecer quais condições o dermatologista pode tratar

Conheça 5 Mitos sobre Contraste em Exames de Imagem
Frequentemente questionáveis por alguns pacientes, entenda e confira alguns mitos sobre contraste em exames de imagem

Resistência ao Tratamento do Câncer de Mama: Veja os Motivos!
Devido a variações de uma proteína, um estudo buscou entender por que alguns pacientes apresentam resistência ao tratamento do câncer de mama

Cientistas Criam Minicérebros para Investigar a Depressão
Uma pesquisa de brasileiros em laboratório utiliza neurônios, células da pele e minicérebros para investigar a depressão

Até 40%: Vacina da Gripe e Covid Reduz Risco de AVC e Infarto
Em estudo envolvendo mais de 2 mil pacientes, comprovou-se a importância da vacina da gripe e Covid-19 na prevenção de doenças